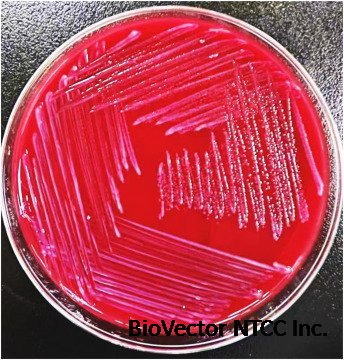
The first case of Odoribacter splanchnicus bacteremia isolated from a  patient in China - ScienceDirect

Odoribacter splanchnicus strain内脏臭杆菌DSM 20712 -BioVector NTCC典型培养物保藏中心
- 价 格:¥99865
- 货 号:NTCC-020712
- 产 地:北京
- BioVector NTCC典型培养物保藏中心
- 联系人:Dr.Xu, Biovector NTCC Inc.
电话:400-800-2947 工作微信:1843439339 (QQ同号)
邮件:Biovector@163.com
手机:18901268599
地址:北京
- 已注册
NTCC's Odoribacter splanchnicus strain DSM 20712 is the type strain of the species Odoribacter splanchnicus. It is a well-characterized anaerobic bacterium with significant interest in the fields of microbiology, gut health, and human disease. Here is a detailed overview of its key features:

General Characteristics
Taxonomy: It belongs to the genus Odoribacter and the family Odoribacteraceae, which are part of the order Bacteroidales. Its full scientific name is Odoribacter splanchnicus (Werner et al. 1975) Hardham et al. 2008 emend. Hahnke et al. 2016.
Synonym: It was previously known as Bacteroides splanchnicus.
Origin: The strain was isolated in 1971 from a human abdominal abscess.
Morphology: It is a Gram-negative, non-motile, non-spore-forming rod-shaped bacterium.
Nomenclature: The name "Odoribacter" means "smelly rod," and "splanchnicus" refers to the "innards" or internal organs, where it was isolated.
Bio-safety Level: It is classified as a Biosafety Level 2 organism, meaning it can be an opportunistic pathogen.
Growth and Metabolism
Anaerobic: This strain is a strict anaerobe, meaning it requires an oxygen-free environment to grow.
Temperature: It grows optimally at 37°C.
Culture Media: It can be cultured in media such as:
DSMZ Medium 110 (Chopped Meat Medium with Carbohydrates): A complex medium that includes ingredients like ground beef, casitone, yeast extract, and various carbohydrates. It is also supplemented with hemin and Vitamin K1.
DSMZ Medium 693 (Columbia Blood Medium): Another suitable medium that includes defibrinated sheep blood.
Growth Factors: Its growth is enhanced by the presence of hemin and bile acid.
Fermentation: It is a chemoorganotroph that can ferment a variety of carbohydrates, including glucose, fructose, galactose, arabinose, lactose, and mannose. However, it cannot ferment sucrose, rhamnose, trehalose, or salicin.
Metabolic Products: It produces short-chain fatty acids (SCFAs), such as acetic, propionic, and succinic acids, as its main fermentation products. It also produces smaller quantities of butyric, isovaleric, and isobutyric acids. It is also known to produce indole and hydrogen sulfide (H2S).
Research Relevance
Human Microbiota:Odoribacter splanchnicus is a common inhabitant of the human intestinal microbiota.
Gut Health: Its production of SCFAs, particularly butyrate, is believed to have health-promoting effects on the gut epithelium, contributing to the maintenance of the epithelial barrier, gut homeostasis, and anti-inflammatory and immunomodulatory activities.
Disease Association: A reduced abundance of Odoribacter has been linked to various microbiota-associated diseases, including inflammatory bowel disease (IBD), non-alcoholic fatty liver disease (NAFLD), and cystic fibrosis.
Genomics: The complete genome sequence of Odoribacter splanchnicus strain DSM 20712 has been fully sequenced and annotated, providing a valuable resource for genetic and metabolic studies. This information is available in databases like KEGG and GenBank.
BioVector NTCC典型培养物保藏中心
- 公告/新闻




